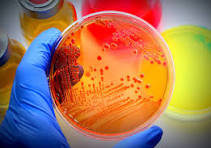

Microbiologie

This course in general microbiology provides the student with the basic concepts of microbiology; it is an entry point to this in-depth science. The learner will have knowledge of bacteria, viruses, and fungi.
- Teacher: Hocine Laredj
This course in general microbiology provides the student with the basic concepts of microbiology; it is an entry point to this in-depth science. The learner will have knowledge of bacteria, viruses, and fungi.